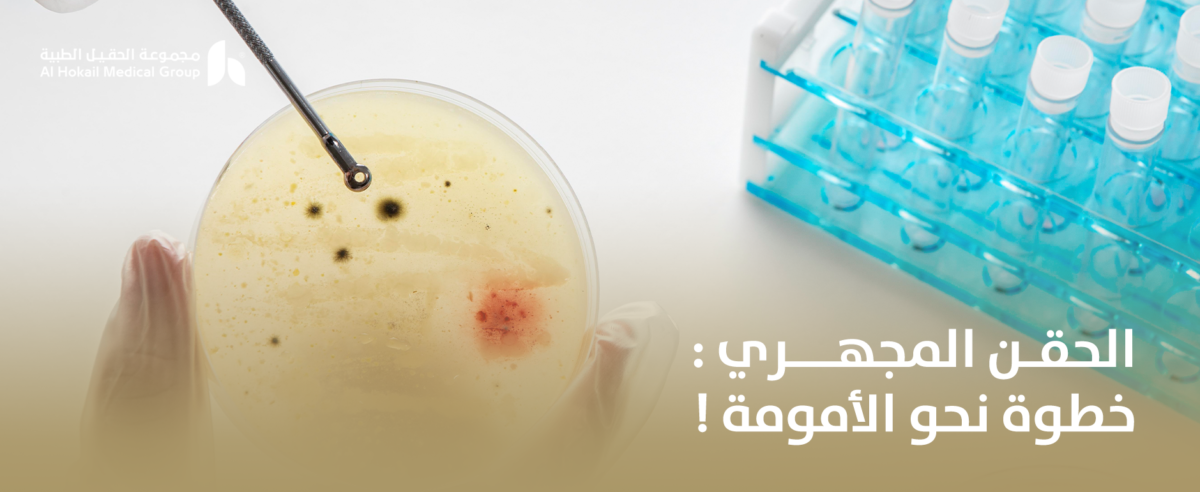
الحقن-المجهري_-خطوة-نحو-الأمومة-1200x492.png

الحقن المجهري: خطوة نحو الأمومة! الحل الأمثل
الحقن المجهري: خطوة نحو الأمومة!
في عيادة الحقيل، حيث تجتمع الخبرة الطبية العميقة مع أحدث تقنيات الإخصاب المساعد، تقود دكتورة سهام العاكوم رحلة الأمل لكل زوجين ينتظران لحظة تحقيق حلم الإنجاب. بخبرة تتجاوز عشرين عامًا في مجال أطفال الأنابيب وعلاج تأخر الحمل، استطاعت أن تساعد مئات الحالات على تجاوز التحديات الطبية بثقة واطمئنان. هنا لا يُنظر إلى العلاج كإجراء تقني فقط، بل كرحلة إنسانية متكاملة تبدأ بالتشخيص الدقيق وتنتهي بمتابعة دقيقة للحمل. ومع كل خطوة مدروسة، يصبح الحقن المجهري: خطوة نحو الأمومة! حقيقة أقرب من أي وقت مضى.
في عيادة الحقيل يتم التعامل مع كل حالة بخصوصية كاملة، لأن أسباب تأخر الحمل تختلف من سيدة إلى أخرى. سواء كانت المشكلة تتعلق باضطرابات هرمونية، أو تكيس المبايض، أو ضعف الحيوانات المنوية، فإن الخطة العلاجية تُبنى على تقييم شامل ودقيق. ومن هنا يبدأ الأمل الحقيقي، لأن الحقن المجهري: خطوة نحو الأمومة! ليس مجرد شعار، بل منهج علاجي متكامل قائم على العلم والخبرة.
لماذا يعتبر التشخيص الدقيق أساس نجاح العلاج؟
قبل البدء في أي برنامج علاجي، يتم التركيز على فهم السبب الحقيقي لتأخر الحمل، لأن العلاج الصحيح يبدأ من التشخيص الصحيح.
تقييم الحالة الهرمونية بشكل شامل
يتم إجراء تحاليل هرمونية دقيقة لتقييم وظائف المبيض والغدة الدرقية وهرمونات التبويض. هذا التقييم يساعد في تحديد مدى انتظام الإباضة واستجابة الجسم للتنشيط. ضبط الهرمونات قبل البدء في أي إجراء يعزز فرص النجاح ويجعل الحقن المجهري: خطوة نحو الأمومة! مبنية على أساس علمي قوي.
فحص مخزون المبيض بدقة
تحليل مخزون المبيض يوضح القدرة المتبقية للمبيض على إنتاج بويضات جيدة. هذا المؤشر مهم جدًا في اختيار بروتوكول التنشيط المناسب، خاصة في الحالات التي تعاني من انخفاض المخزون أو تقدم العمر. التخطيط الصحيح منذ البداية يزيد من فرص تكوين أجنة سليمة.
تقييم السائل المنوي وعلاج مشكلات الذكورة
في كثير من الحالات يكون سبب تأخر الحمل مرتبطًا بضعف الحيوانات المنوية. يتم إجراء تحليل شامل للسائل المنوي، وفي حال وجود مشكلة يتم اختيار التقنية المناسبة لضمان أفضل فرص إخصاب داخل المختبر. بهذه الطريقة يصبح الحقن المجهري: خطوة نحو الأمومة! حلًا فعالًا حتى في أصعب الحالات.
مراحل برنامج الحقن المجهري: خطوة نحو الأمومة! بالتفصيل
فهم خطوات العلاج يساعد في تقليل القلق ويمنح شعورًا أكبر بالاطمئنان والثقة.
تنشيط المبايض وفق بروتوكول مخصص
يتم إعطاء أدوية منشطة للمبيض لتحفيزه على إنتاج عدد مناسب من البويضات. تختلف الجرعات حسب عمر السيدة ومخزون المبيض وحالتها الصحية. تتم المتابعة بالموجات فوق الصوتية وتحاليل الدم لضبط الجرعات بدقة. الهدف هو الحصول على بويضات ذات جودة عالية، لأن الجودة هي الأساس في نجاح الحقن المجهري: خطوة نحو الأمومة!
سحب البويضات وإجراء التلقيح المجهري
عند وصول البويضات إلى الحجم المناسب، يتم سحبها بإجراء بسيط تحت تخدير خفيف. بعدها يتم حقن كل بويضة ناضجة بحيوان منوي واحد داخل المختبر باستخدام تقنيات دقيقة للغاية. هذه الخطوة تزيد من فرص الإخصاب حتى في حالات الضعف الشديد في الحيوانات المنوية.
متابعة الأجنة داخل المختبر
بعد الإخصاب، تتم مراقبة الأجنة يوميًا لتقييم انقسامها وجودتها. اختيار الأجنة يتم وفق معايير دقيقة تركز على فرص الانغراس والنمو السليم. في بعض الحالات يتم استخدام تقنيات داعمة مثل الليزر لتحسين فرص الالتصاق ببطانة الرحم، مما يعزز نجاح الحقن المجهري: خطوة نحو الأمومة!
دور الفحص الوراثي في تعزيز فرص الحمل السليم
التطور العلمي أتاح إمكانية فحص الأجنة وراثيًا قبل إرجاعها إلى الرحم، وهو خيار مهم في بعض الحالات.
الكشف عن الاضطرابات الكروموسومية
يتم أخذ عينة دقيقة جدًا من الجنين لتحليلها مخبريًا، بهدف التأكد من سلامة التركيب الكروموسومي. هذا الإجراء يقلل من احتمالية الإجهاض ويزيد من فرص الحمل المستقر.
اختيار الأجنة السليمة للنقل
الفحص الوراثي يساعد في اختيار الأجنة ذات أعلى فرصة للانغراس والنمو الطبيعي، مما يعزز نسبة النجاح ويجعل الحقن المجهري: خطوة نحو الأمومة! أكثر أمانًا واطمئنانًا.
تحديد جنس الجنين وفق الضوابط الطبية
عند رغبة الزوجين، يمكن تحديد جنس الجنين من خلال التحليل الوراثي قبل الإرجاع، مع الالتزام بالمعايير الطبية الدقيقة. يتم اختيار الأجنة السليمة من الجنس المطلوب دون التأثير على جودة النقل.
التعامل مع الحالات المعقدة وتأخر الحمل الطويل
ليست كل الحالات متشابهة، فبعضها يحتاج إلى خبرة خاصة وخطة علاج متقدمة.
انسداد قنوات فالوب
في حال انسداد الأنابيب، يعتبر الحقن المجهري الخيار الأمثل، لأن الإخصاب يتم خارج الجسم ثم يُعاد الجنين مباشرة إلى الرحم. بهذه الطريقة لا يشكل الانسداد عائقًا أمام الحمل.
انخفاض مخزون المبيض
تستقبل دكتورة سهام العاكوم حالات انخفاض مخزون المبيض، ويتم وضع بروتوكولات تنشيط خاصة تركز على تحسين جودة البويضات المتاحة. المتابعة الدقيقة تعزز الاستفادة القصوى من كل فرصة.
اضطرابات الهرمونات وتكيس المبايض
يتم علاج التكيس واضطرابات الهرمونات بخطط مخصصة قبل بدء برنامج الإخصاب. تهيئة الجسم بشكل صحيح يزيد من فرص الاستجابة ويقوي احتمالية النجاح.
عدد البويضات وجودتها وأثرهما في نجاح العلاج
نجاح برنامج الإخصاب لا يعتمد فقط على العدد، بل على جودة البويضات ومدى جاهزيتها للإخصاب.
كيفية تحديد عدد البويضات المناسبة للتلقيح
خلال مرحلة التنشيط، يهدف الطبيب إلى الحصول على عدد جيد من البويضات الناضجة دون تعريض السيدة لمضاعفات. لا يوجد رقم ثابت يناسب الجميع، إذ يختلف العدد حسب العمر ومخزون المبيض واستجابة الجسم للأدوية. يتم تلقيح البويضات الناضجة فقط، ما يضمن أفضل فرص تكوين أجنة قوية. وعندما يتم التخطيط بدقة، يصبح الحقن المجهري: خطوة نحو الأمومة! مبنيًا على توازن بين الكمية والجودة.
أقصى عدد من البويضات الممكن تلقيحها
من الناحية الطبية، يمكن تلقيح جميع البويضات الناضجة التي يتم سحبها، بشرط أن تكون صالحة للإخصاب. الهدف ليس زيادة العدد فقط، بل ضمان تكوين أكبر عدد ممكن من الأجنة السليمة. وجود عدد أكبر من الأجنة الجيدة يمنح فرصة للاختيار الأفضل أو التجميد لمحاولات لاحقة، مما يرفع فرص النجاح التراكمي.
جودة الأجنة أهم من العدد
قد تحصل بعض الحالات على عدد كبير من البويضات لكن بجودة متوسطة، بينما قد تحقق حالات أخرى نجاحًا ببويضات أقل ولكن بجودة ممتازة. لذلك تركز دكتورة سهام العاكوم على تحسين البيئة الهرمونية واختيار بروتوكول تنشيط يناسب كل سيدة، لأن الجودة العالية تعزز ثبات الحمل وتجعل الحقن المجهري: خطوة نحو الأمومة! أكثر أمانًا واستقرارًا.
تشخيص الأجنة وراثيًا وأهميته في تقليل المخاطر
التقدم الطبي في مجال الوراثة أتاح فحص الأجنة قبل إرجاعها إلى الرحم، وهو خيار مهم في بعض الحالات الخاصة.
الكشف عن اضطرابات الكروموسومات مثل تربل اكس
من الاضطرابات الوراثية المعروفة متلازمة الكروموسوم الثلاثي X، والتي تنتج عن وجود نسخة إضافية من كروموسوم X لدى الأنثى. الفحص الوراثي قبل الإرجاع يساعد في استبعاد الأجنة التي تحمل اضطرابات كروموسومية واضحة، مما يقلل من احتمالية الإجهاض أو المشكلات الصحية المستقبلية.
استقصاء بعض الأمراض الوراثية المعروفة
في حال وجود تاريخ عائلي لأمراض وراثية معينة، يمكن إجراء تحليل متخصص على الأجنة لاختيار الأجنة السليمة. هذه التقنية تمنح طمأنينة أكبر للزوجين، خاصة في الحالات التي سبق لها التعرض لإجهاض متكرر أو ولادة طفل مصاب بمرض وراثي.
دور الفحص في تحسين نسب النجاح
عند نقل جنين سليم وراثيًا، تقل احتمالية فشل الانغراس أو توقف نمو الحمل في مراحله الأولى. لذلك يُعد الفحص الوراثي أحد العوامل التي تعزز استقرار الحمل وتزيد من نسب النجاح، مما يجعل الحقن المجهري: خطوة نحو الأمومة! مبنيًا على دقة علمية متقدمة.
تحديد الجنس ضمن برامج الإخصاب المساعد
تحديد جنس الجنين يتم من خلال تحليل الأجنة وراثيًا قبل النقل، وليس من خلال التلقيح الصناعي التقليدي فقط.
آلية تحديد الجنس في المختبر
بعد تكوين الأجنة، يتم تحليلها مخبريًا لمعرفة التركيب الكروموسومي لكل جنين، ومن ثم اختيار الجنين السليم من الجنس المرغوب. هذه العملية تتم وفق ضوابط طبية وأخلاقية واضحة، مع التركيز أولًا على سلامة الجنين وجودته.
عدد الأجنة التي يمكن الاختيار من بينها
كلما كان عدد الأجنة السليمة أكبر، زادت احتمالية توفر جنين من الجنس المطلوب مع جودة عالية. لذلك يرتبط نجاح تحديد الجنس بشكل غير مباشر بعدد وجودة البويضات التي تم تخصيبها.
الفرق بين التلقيح الصناعي والحقن المجهري في تحديد الجنس
التلقيح الصناعي لا يسمح بتحليل الأجنة قبل الإرجاع، بينما في الحقن المجهري: خطوة نحو الأمومة! يمكن فحص الأجنة واختيار الأنسب طبيًا وجنسيًا عند الحاجة.

حالات خاصة واستجابات مختلفة للعلاج
كل حالة لها ظروفها الخاصة، لذلك يتم تصميم الخطة العلاجية بعناية فائقة.
انسداد الأنابيب وإمكانية العلاج
في حال انسداد قنوات فالوب، لا يمكن حدوث حمل طبيعي بسبب صعوبة التقاء البويضة بالحيوان المنوي. هنا يأتي دور الإخصاب خارج الجسم، حيث يتم تجاوز الأنابيب بالكامل، مما يجعل الحقن المجهري: خطوة نحو الأمومة! الحل الأكثر فاعلية لهذه الحالات.
انخفاض مخزون المبيض
تستقبل دكتورة سهام العاكوم حالات انخفاض مخزون المبيض، ويتم التعامل معها ببروتوكولات دقيقة تركز على تعظيم الاستفادة من البويضات المتاحة. أحيانًا يتم اللجوء إلى تنشيط مخصص أو خطط علاج داعمة لتحسين جودة البويضات.
إمكانية الحمل الطبيعي أثناء التنشيط
رغم أن الهدف من التنشيط هو التحضير لسحب البويضات، قد يحدث حمل طبيعي في بعض الحالات إذا توافرت الظروف المناسبة قبل السحب. لذلك يتم توجيه الزوجين وفق الحالة الطبية بدقة لضمان أفضل النتائج.
إن رحلة العلاج داخل عيادة الحقيل تحت إشراف دكتورة سهام العاكوم ليست مجرد خطوات طبية، بل هي مسار شامل يجمع بين الخبرة الطويلة، التكنولوجيا المتقدمة، والرعاية الإنسانية الدقيقة. كل مرحلة من مراحل الحقن المجهري مُخطط لها بعناية فائقة بدءًا من التشخيص الدقيق، مرورًا بتنشيط المبايض، الإخصاب في المختبر، الفحص الوراثي، وصولًا إلى نقل الأجنة ومتابعة الحمل. هذه الخطة المخصصة تضمن أقصى فرص نجاح لكل زوجين يسعى لتحقيق حلم الإنجاب.
مع الدعم النفسي والطبي المستمر، يصبح الحقن المجهري: خطوة نحو الأمومة! تجربة مبنية على الثقة، المعرفة، والاحترافية، حيث يتم التعامل مع كل حالة بخصوصية تامة لضمان أفضل النتائج. إذا كنتِ تبحثين عن طبيبة ذات خبرة طويلة ونتائج مثبتة، فإن دكتورة سهام العاكوم هي الخيار الأمثل، لتبدئي رحلة الأمل نحو الأمومة بثقة وطمأنينة.
الأسئلة الشائعة
إذا كانت الأنابيب مسدودة، هل يمكن إجراء حقن مجهري؟
نعم، عند انسداد قنوات فالوب يتم إجراء الإخصاب خارج الجسم في المختبر، ثم يتم نقل الجنين مباشرة إلى الرحم. هذه الطريقة تجعل الحمل ممكنًا حتى في حالات انسداد الأنابيب.
هل يمكن الحمل طبيعيًا خلال فترة المعالجة والتنشيط؟
في بعض الحالات قد يحدث حمل طبيعي إذا تم التبويض بشكل طبيعي وتزامنت العلاقة الزوجية مع الفترة المثالية. لكن غالبًا يتم التحكم في الإباضة ضمن البروتوكول الطبي لضمان أفضل النتائج للحقن المجهري.
عند تحديد جنس الجنين، كم بويضة يتم تلقيحها وهل العدد محدود؟
يتم تلقيح جميع البويضات الناضجة التي تم سحبها، وليس هناك عدد محدد. بعد تكوين الأجنة يتم اختيار الأفضل وراثيًا والجنس حسب الرغبة الطبية، مما يزيد من فرص النجاح.
ما هو أقصى عدد من البويضات الممكن تلقيحها؟
يعتمد العدد على استجابة المبيض للبروتوكول العلاجي وعلى عدد البويضات الناضجة المتاحة. التركيز الأساسي يكون على جودة البويضات وليس على العدد فقط لضمان أفضل نتائج.
ما هو مرض تربل إكس؟
تربل إكس هو اضطراب كروموسومي ينتج عن وجود نسخة إضافية من كروموسوم X عند الأنثى. يمكن اكتشافه عبر الفحص الوراثي للأجنة قبل النقل لتجنب الأجنة التي تحمل اضطراب كروموسومي واضح.
هل يمكن استقصاء مرض التوحد عبر الفحص الوراثي؟
الفحص الوراثي يساعد في كشف بعض الأمراض الوراثية والكروموسومية، لكنه لا يغطي جميع أسباب التوحد نظرًا لتعدد عوامل الإصابة وعدم ارتباطه بجين واحد فقط.
هل تستقبل الدكتورة حالات انخفاض مخزون المبيض؟
نعم، يتم وضع بروتوكولات خاصة لهذه الحالات مع متابعة دقيقة لتعظيم الاستفادة من البويضات المتاحة وتحسين فرص الحمل.
اقرئي مقالاتنا المتخصصة واطّلعي على أحدث طرق تشخيص وعلاج العقم للنساء


